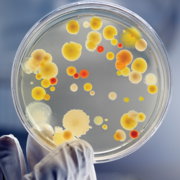

Learn 211
Study 211 using smart web & mobile flashcards created by top students, teachers, and professors. Prep for a quiz or learn for fun!
Brainscape Certified flashcards
(0)
Decks
Flashcards
Learners
User Generated flashcards
(30)
Decks
Flashcards
Learners
-
chem 211
chem 211
By: Mary Alphonse
ch 1, ch 2, ch 3 ...4Decks100Flashcards1Learner -
PSYC 211

PSYC 211
By: Laura Parodi
Origins of Behavioural Neuroscience, Structure and Functions of Cells of the Nervous System, Structure of the Nervous System ...4Decks326Flashcards2Learners -
PSCI 211
PSCI 211
By: olivia borbridge
final exam1Decks38Flashcards1Learner -
211
211
By: Lauren Withers
Chapter 1 - Determinants, Chapter 2 - Chain Rules, Chapter 3 - Triple Integrals ...12Decks137Flashcards2Learners -
St 211 lab
St 211 lab
By: Myah Schulte
General surgery, OB/GYN, Plastics ...5Decks71Flashcards1Learner -
PSYC 211 (Behavioural Neuroscience)
PSYC 211 (Behavioural Neuroscience)
By: Kristen S
Vision, Body Senses & Chemicals, Introduction Part 1 ...4Decks255Flashcards6Learners -
AEBI 211: Organisms 2
AEBI 211: Organisms 2
By: Emile Derbesy-Lanari
Evolution, Reproduction, Circulation ...31Decks451Flashcards1Learner -
211 - Cardio - Raquel
211 - Cardio - Raquel
By: Sofia Sacramento
267. Exame Fisico Cardiovascular, 277. Arritmias Ventriculares, 268 ECG ...14Decks375Flashcards1Learner -
Biology 211
Biology 211
By: Eddie Urtiaga
Midterm 1, Midterm 2, Midterm 3 ...5Decks687Flashcards1Learner -
Eng 211

Eng 211
By: Amanda Ott
Week 2, Module 2, Phonology Key Terms ...7Decks236Flashcards1Learner -
Biol 211 - Cell Biology
Biol 211 - Cell Biology
By: Deleted Deleted
P-type pumps Essay, GTP Binding Proteins In Signalling, The Cytoskeleton ...4Decks45Flashcards2Learners -
CHEM 211

CHEM 211
By: Dee Reyes
Potentiometry Parts 1 and 2, Potentiometry Parts 3 and 4, Spectroscopy Part 1 ...5Decks113Flashcards1Learner -
microbiology 211
microbiology 211
By: Emily Ryan
Exam 1, Exam 2, Lab Practical 1 ...6Decks362Flashcards2Learners -
ANCIENT 211
ANCIENT 211
By: Jamie Y. Ji
GE 1A-B1Decks24Flashcards1Learner -
Eng 211 Introduction to Linguistics Fall 2021

Eng 211 Introduction to Linguistics Fall 2021
By: David Mulvihill
Intro to linguistics, International Phonetic Alphabet, Phonology ...7Decks248Flashcards5Learners -
Bible 211
Bible 211
By: Courtney Baker
Test1.Quizes, Test1.WhoAmI, Test1.WhoAmI2 ...6Decks132Flashcards3Learners -
POLS 211
POLS 211
By: Annika Boganes
European Countries & Capitals, African Countries & Capitals, Asian Countries & Capitals ...6Decks215Flashcards2Learners -
SPAN 211
SPAN 211
By: Samantha Carraway
Test 1 Vocab, Test 1 Conjugations2Decks78Flashcards1Learner -
BIOL211 Cell Biology

BIOL211 Cell Biology
By: Anonymous Female
Cytoskeleton, Microtubules, Microtubule Motor Proteins ...19Decks498Flashcards2Learners -
EC 211
EC 211
By: Unknown Unknown
EC 211 FIRST TEST1Decks25Flashcards1Learner -
EDU 211
EDU 211
By: Nesta Archeron
EDU 211 Terminology1Decks24Flashcards1Learner -
hist 211
hist 211
By: Nicole Cantea
midterm1Decks27Flashcards1Learner -
ACCTG 211
ACCTG 211
By: Michelle Unknown
Chap. 2.31Decks17Flashcards1Learner -
Microbiology 211 Lab
Microbiology 211 Lab
By: Carel Anorve
Quiz 1, Quiz 2, Quiz 2 Updated ...5Decks270Flashcards2Learners -
English 211
English 211
By: Abigail Prieto
Vocabulary, Chapter 2, Chapter 3 Vocabulary ...6Decks202Flashcards2Learners -
Eng 211
Eng 211
By: Stephanie Ponce
Phonetic, Phonology, Morophology ...6Decks198Flashcards2Learners -
BI 211 Genetics

BI 211 Genetics
By: Pedro Martinez
Genetics1Decks77Flashcards1Learner -
ASL 211
ASL 211
By: Molly Stetsko
Midterm, Final2Decks52Flashcards3Learners -
ANSC 211
ANSC 211
By: Annie Johnson
Fats, Amino Acids2Decks21Flashcards1Learner -
Nursing 211 - Statistics and Knowledge Management
Nursing 211 - Statistics and Knowledge Management
By: Melissa Brown
Levels of Measurement Practice1Decks20Flashcards7Learners



